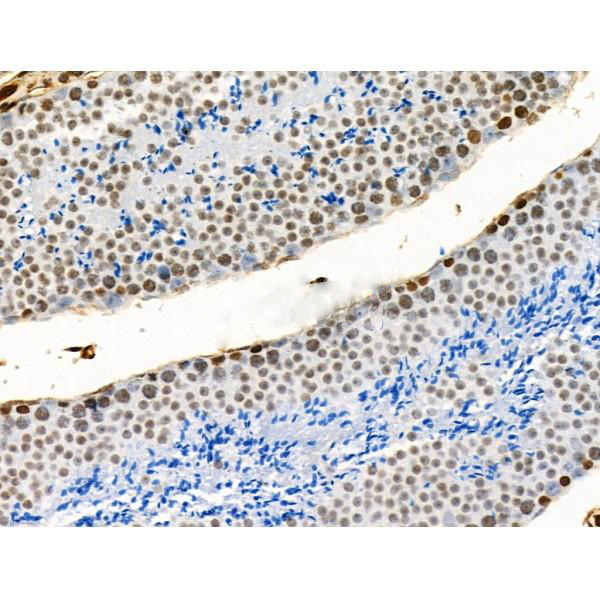

Variant histone H2A which replaces conventional H2A in a subset of nucleosomes. Nucleosomes wrap and compact DNA into chromatin, limiting DNA accessibility to the cellular machineries which require DNA as a template. Histones thereby play a central role in transcription regulation, DNA repair, DNA replication and chromosomal stability. DNA accessibility is regulated via a complex set of post-translational modifications of histones, also called histone code, and nucleosome remodeling. May be involved in the formation of constitutive heterochromatin. May be required for chromosome segregation during cell pision.
Description
Rabbit polyclonal antibody to Acetyl-H2A.Z (Lys4/7/11/13)
Applications
WB, IHC.
Immunogen
Acetyl-H2A.Z (Lys4/7/11/13) Antibody detects endogenous levels of Acetyl-H2A.Z only when acetylated at Lys4/7/11/13.
Reactivity
Human, Mouse, Rat.
可预测:Bovine(100%), Sheep(100%), Dog(100%), Chicken(100%), Xenopus(91%)
Molecular weight
14kDa; 14kD(Calculated).
Host species
Rabbit
Ig class
Immunogen-specific rabbit IgG
Purification
Antigen affinity purification
Full name
ABHD7
Synonyms
H2A histone family member Z; H2A.z; H2A/z; H2afz; H2AZ; H2AZ_HUMAN; Histone H2A.Z; MGC117173;
Storage
Rabbit IgG in phosphate buffered saline , pH 7.4, 150mM NaCl, 0.02% sodium azide and 50% glycerol. Store at -20 °C. Stable for 12 months from date of receipt.
Swissprot
P0C0S5




 产品订购:
产品订购:
 渠道电话:
渠道电话: